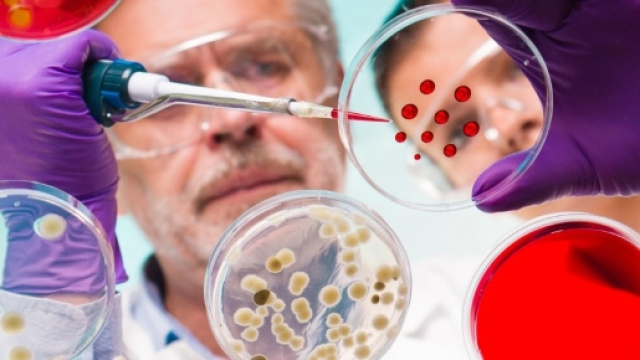
Batteri resistenti agli antibiotici, minaccia peggiore del ... - panorama.it

Non vi è dubbio che la scoperta degli antibiotici abbia rivoluzionato la storia della medicina moderna. Prima della scoperta di questi farmaci, anche quella che oggi possiamo considerare una banale ferita, infettandosi poteva rivelarsi fatale. D'altronde però ormai da anni sono stati scoperti dei batteri sempre più resistenti agli antibiotici. Si tratta di un fenomeno sempre più diffuso che riguarda anche il nostro Paese. L'allarme in particolare viene da un gruppo di ricercatori che hanno partecipato a un congresso dell'American Society for microbiology.
Si tratta di un vero e proprio appello che non deve essere trascurato o sottovalutato da parte dei governi nazionali e dalle organizzazioni sanitarie dei vari paesi.
Nuovo batterio-super resistente agli antibiotici
I ricercatori hanno isolato un batterio contenente un gene chiamato Mcr-1, che è stato scoperto 18 mesi fa. Questo agente patogeno è stato identificato nel 25% dei pazienti ricoverati in alcuni ospedali cinesi, ed anche negli Stai Uniti e in altri 20 paesi ancora. Ma quel che più preoccupa i ricercatori sono due fattori: il batterio si sta diffondendo in tutto il mondo a grande velocità ed inoltre questo batterio contenente il gene Mcr-1 risulta resistente alla Colistina, l'antibiotico di ultima linea quando tutti gli altri falliscono contro i batteri multi-resistenti.
Lo scenario che i ricercatori paventano è a tinte fosche: in pratica l'ipotesi tutt'altro che infondata è che in un futuro prossimo anche infezioni che oggi consideriamo ancora banali oppure operazioni chirurgiche di routine quali l'appendicectomia, potrebbero rappresentare un rischio molto elevato per la vita dei pazienti. Insomma si rischia davvero di catapultare indietro nel tempo le lancette del progresso scientifico.
Perché i batteri sono diventati resistenti agli antibiotici
D'altronde negli ultimi decenni l'uso indiscriminato degli antibiotici, soprattutto quando non necessari, ha contribuito alla creazione di agenti patogeni che hanno sviluppato una resistenza a questi farmaci, divenendone in pratica insensibili.
Proprio a causa di ciò, i medici hanno iniziato a far ricorso nuovamente alla Colistina, un farmaco che si utilizzava fino agli anni 50', ma che in seguito venne abbandonato nella pratica medica a causa dei pesanti effetti collaterali a carico dei reni. Tale farmaco è stato di nuovo utilizzato quindi per il trattamento dei batteri multi-resistenti. Riguardo alla fondatezza di questo pericolo, basta solo tenere conto che attualmente ogni anno nel mondo muoiono 700mila persone a causa di infezioni che risultano resistenti agli antibiotici e che stando alle ultime previsioni nel 2050 questo numero arriverà a 50 milioni. Se volete rimanere sempre informati sulle news riguardanti la salute cliccate in alto a destra il tasto Segui accanto al nome dell'autore dell'articolo.